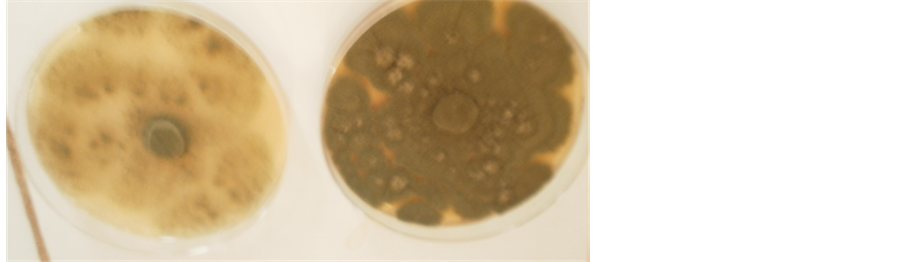
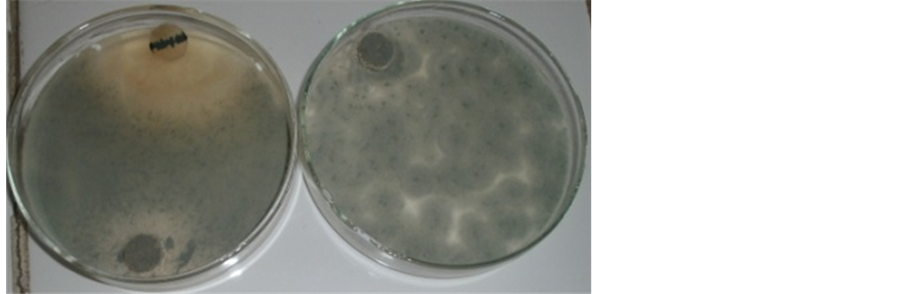
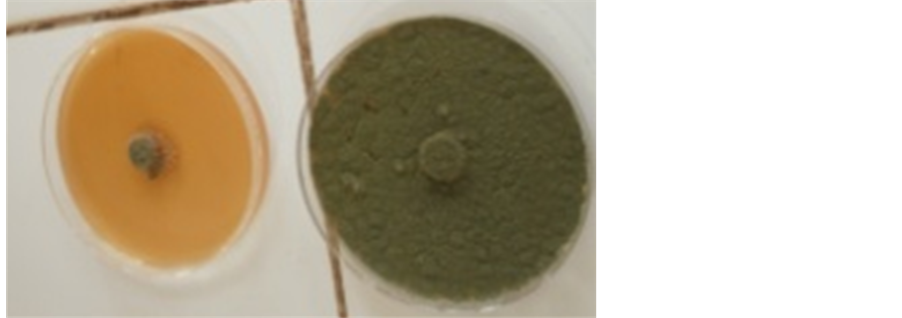
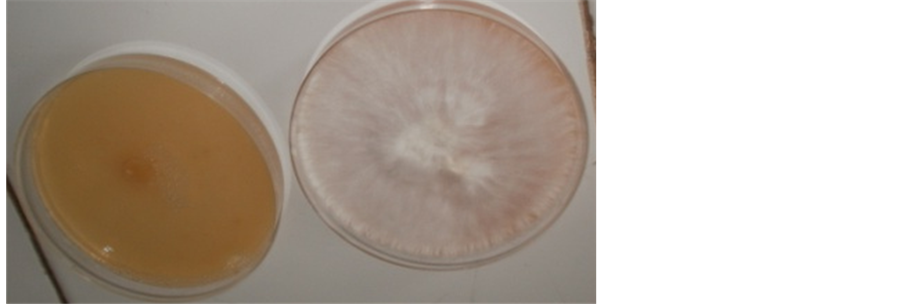

Advances in Microbiology
Vol.05 No.04(2015), Article ID:55934,10 pages
10.4236/aim.2015.54024
In Vitro Antifungal Efficacies of Maize Associated Microorganisms
Esther Aanuoluwa Ekundayo1,2*, Bolatito Esther Boboye2, Fatusa Clement Adetuyi2
1Department of Biological Sciences, Microbiology Unit, Afe Babalola University, Ado-Ekiti, Nigeria
2Department of Microbiology, Federal University of Technology, Akure, Nigeria
Email: *esttydayo2010@yahoo.co.uk
Copyright © 2015 by authors and Scientific Research Publishing Inc.
This work is licensed under the Creative Commons Attribution International License (CC BY).
http://creativecommons.org/licenses/by/4.0/



Received 14 February 2015; accepted 17 April 2015; published 24 April 2015
ABSTRACT
Microorganisms (bacteria and fungi) were isolated from different parts of yellow maize (stem, cob, husk, leaf, root) as well as from rhizosphere and non-rhizosphere soil of maize using conventional microbiological techniques. A total number of twenty-six bacteria and thirteen fungi were isolated. The antagonistic efficacies of these isolates were tested against Sclerotium rolfsii, Aspergillus repens, Penicillium notatum and Pythium sp. using streak bioassay, food poisoning and dual culture techniques. None of the bacteria was antagonistic to the test fungi at 25˚C on PDA using streak bioassay. However, there was reduction in the population density of the test fungi using food poisoning technique. The fungal isolates were antagonistic to the test fungi in varying degrees. Generally, S. rolfsii was susceptible to seven out of the eight fungal antagonists while P. notatum was least susceptible. The percentage reduction of S. rolfsii ranged from 40.00 ± 5.78 to 64.07 ± 2.31. Efficacies of chemical fungicides; mancozeb, camazeb and red force at 3 different concentrations― 0.05%, 0.1% and 1.0% (w/v) on the test fungi were also determined. No growth of the test fungi was observed at 1% (w/v) of all the fungicides while at lower concentration (0.05%), red force did not have any inhibitory effect. The growth of S. rolfsii was completely inhibited at 0.05% of mancozeb whereas there was reduction in mycelial growth of A. repens. Effect of inoculation time and nutrients (PDA and MEA) was determined on the antagonistic activities of Trichoderma viride. There were significant differences in inhibitory potentials of the two isolates of Trichoderma viride when pre-inoculated on the culture medium. The antagonistic potentials were more pronounced on malt extract agar than potato dextrose agar.
Keywords:
Microorganisms, Antagonistic Activities, Chemical Fungicides

1. Introduction
Crops are usually affected by phytopathogenic fungi and fungal diseases are difficult to control without the use of synthetic fungicides [1] . However, the application of large quantities of chemicals in agriculture has the potential to exert toxic effects on humans and wildlife as well as to cause environmental pollution [2] . Also, increasing use of chemicals causes several negative effects, i.e., development of pathogen resistance to the applied agents and their non target environmental impacts [3] . Furthermore, the growing cost of pesticides and consumer demand for pesticide-free food has led to a search for substitutes for these products. There are also a number of fastidious diseases for which chemical solutions are few, ineffective, or nonexistent [3] .
Biological control treatment consisting of living microorganisms or abiotic products can provide disease protection essentially through one or more of the following: production of antibiotics or other molecules that are deleterious to the pathogen’s development, competition with the pathogen for nutrients and space or induced plant resistance [4] . It is well established that there are large and diverse numbers of bacteria found on plants and a diverse set of bacteria have been identified with biocontrol activities [5] . The use of bacteria as biocontrol agents of foliar disease of cereals has been reported to be an alternative of great potential [6] . Fungi have received most attention as antagonists possibly because they are easier to handle and identify than bacteria and actinomycetes [7] . Studies on the use of maize associated microorganisms in Nigeria are not common, therefore the present investigation is aimed at determining the antifungal potencies of maize associated microorganisms.
2. Materials and Methods
2.1. Source of Maize
Maize ears, stem, root, leaf, rhizosphere and non rhizosphere soils were collected from a farm located at the Federal University of Technology Junior staff quarters, Akure, Ondo State, Nigeria.
2.2. Fungicides
Mancozeb and red force were purchased from Akure while camazeb was kindly supplied by Dr. F. O. Ekundayo of the Department of Microbiology, Federal University of Technology, Akure.
2.3. Fungal Isolates
Pythium sp. and Aspergillus repens were collected from Institute of Agricultural Research and Training, Ibadan, Oyo State, Nigeria while Sclerotium rolfsii was collected from the Department of Crop Soil and Pest Management, Federal University of Technology, Akure (FUTA). Also, Penicillium notatum was isolated from spoilt yam and identified by Mr. Akharaiyi of the Department of Biological Sciences, Microbiology option, Afe Babalola University, Ado-Ekiti, Nigeria.
2.4. In Vitro Antagonistic Effects of the Bacterial Isolates on the Selected Crop Fungal Pathogens
1) Streak Bioassay
A plug of each fungal mycelium (7 mm) was inoculated onto the centre of a potato dextrose agar (PDA) plate and a 40 mm streak of each bacterium was then made 23 mm from the fungal plug. Plates were then incubated for 5 days at 25˚C. Plates without bacterial streak were used as controls. Measurement of the fungal growth was according to Adetuyi [8] , Bhaskar et al. [9] and Daayf et al. [4] .
2) Food Poisoning Technique
Different quantities (1, 2, 3, 4, and 5 ml) of each bacterium were incorporated into sterile PDA medium following Caldari Junior [10] . Afterwards, discs of mycelium-agar with isolates of the phytopathogen were inoculated in medium containing fungicides, with three repetitions for each treatment; including control inoculated in fungicide-free medium and maintained at 25˚C. Mycelial growth was measured on the 5th day to evaluate the biological control and alterations in macroscopic aspects of colonies.
2.5. In Vitro Antagonistic Effects of the Fungal Isolates on the Selected Crop Fungal Pathogens Using Dual Culture Technique
The test pathogens and fungal isolates were studied using dual culture plate technique under in vitro condition. The agar block cut from actively growing margin of individual species of fungal isolates and test organisms were inoculated in opposite direction to each other on potato dextrose agar medium in petriplates. Three replicates for each set were maintained. The rate of mycelium growth of each isolate in such a way that the colonies could reach simultaneously the center of the plate. Measures were carried out in opposite directions until the meeting of the two mycelia and/or until one of the two fungi were overlaid by the other [11] . Percentage reduction in the mycelia of the fungal pathogens was calculated using this formula:

where, C = radial growth in control set; T = radial growth in treated set.
2.6. Effect of Some Fungicides on the Selected Test Pathogens
Three fungicides were selected for the present study; mancozeb, camazeb and red force. These were incorporated into PDA medium following Caldari Junior [10] in three different concentrations (0.05%, 0.1% and 1%). Afterwards, discs of mycelium-agar with isolates of the phytopathogen were inoculated in medium containing fungicides, with three repetitions for each treatment; including control inoculated in fungicide-free medium and maintained at 25˚C. Mycelial growth was measured on the 5th day to evaluate the chemical control and alterations in macroscopic aspects of colonies. The data were submitted to statistical analysis in order to compare the efficiency of fungicides. The experiment was arranged in a complete randomized 4 × 3 × 3 factorial scheme represented by four isolates of pathogen; three fungicides; three concentrations of active ingredient with three repetitions for each treatment, and control.
2.7. Effect of Nutrient Media on Antagonistic Ability of Fungal Isolates
Potato dextrose agar and malt extract agar (MEA) were selected to determine their effects on the antagonistic property of the fungal isolates. The media were prepared according to the manufacturer’s specification after which the dual culture previously described was used.
2.8. Effects of Time on Antagonistic Activities of the Fungal Isolates
Based on the consistency of the antagonistic property of T. viride, it was selected for further studies. Trichoderma species were cultured on sterile potato dextrose agar plates a day and 2 days before inoculation of the selected pathogens [12] (Spotts and Chand-Goyal, 1997). The plates were then incubated at 25˚C for 5 days after which percentage inhibition was calculated.
2.9. Statistical Analysis of Data
The data collected were then subjected to analysis of variance (ANOVA) using SPSS version 11 Microsoft Windows xp. The means were separated using Duncan’s Range Multiple Test at P = 0.05.
3. Results
3.1. Isolation of Microorganisms
A total number of twenty-six (26) bacterial species were isolated. Twenty-four of the isolates were Gram positive while two were negative. Majority of the isolates were Gram positive bacilli, two were negative bacilli identified as Serratia mascenscens and Pseudomonas sp. while the remaining ones were Gram positive cocci. Thirteen fungal isolates were obtained from the samples and were identified as Thysonaphora longispora, Trichoderma species, Staphylotrichum sp., Aspergillus flavus, Stachylidium, Hirsutella saussurei, Hirsutella saussurei, Penicillium italicum, Gonatobotryum apiculatum, Trichoderma viride, Condropodium pseudotsugae and Aspergillus niger.
3.2. Effects of the Bacterial Isolates on the Test Pathogens
None of the bacterial isolates was antagonistic but stimulatory to the test pathogens using streak bioassay at 25˚C on PDA. All the test pathogens overgrew the bacterial isolates as shown on Figure 1 to Figure 2. The mycelial growth of the culture plates challenged by the antagonists and the control were the same as shown in Table 1. The results of the antagonistic properties of the test pathogens using poisoning technique also show that none of the bacterial isolates was inhibitory/but there was reduction in the mycelial growth and spore formation even at higher concentrations of the bacterial antagonists as shown on Figure 3.
3.3. Effects of the Fungal Isolates on the Test Pathogens
All the test pathogens showed varying degrees in their susceptibility to the fungal isolates as shown in Figure 4 and Figure 5. Generally, P. notatum was least susceptible to the fungal antagonists. The radial growth of the culture plates that were challenged by the fungal antagonists and percentage reduction of their growth are shown in Tables 2-5.
3.4. Effect of Selected Fungicides on the Test Fungal Pathogens
No growth of the test fungi was observed 1% of the active ingredient as shown in Figure 6 and Figure 7. However, at lower concentration (0.05%), red force did not have any inhibitory effect on the test pathogens but there was reduction in the mycelial growth of S. rolfsii and A. repens when camazeb was used. The growth of S. rolfsii was completely inhibited at 0.05% of mancozeb whereas there was reduction in mycelial growth of A. repens as shown in Table 6.

Figure 1. Antifungal effect of bacterial isolate on Sclerotium rolfsii on PDA at 25˚C. (a) Bacterium + Sclerotium rolfsii; (b) Sclerotium rolfsii only.

Figure 2. Antifungal effect of bacterial isolate on Sclerotium rolfsii on PDA at 25˚C. (a) Bacterium + Sclerotium rolfsii; (b) Sclerotium rolfsii only.
Table 1. In vitro evaluation of the antagonistic activities of maize associated bacteria against selected fungal pathogens by dual technique on PDA at 25˚C.
Figure 3. Antifungal effect of bacterial isolate against Aspergillus repens on PDA at 25˚C by food poisoning technique. (a) Bacterium + Aspergillus repens; (b) Aspergillus repens only.
3.5. Effect of Nutrient on the Antagonistic Property of T. viride
All the media used supported the growth of both the pathogens and T. viride. However, the growth of S. rolfsii and T. viride was more pronounced when malt extract agar was used (Plate 8). There was increase in percentage

Figure 4. Antagonistic activities of Trichoderma viride against Sclerotium rolfsii on PDA at 25˚C. (a) Trichoderma viride + Sclerotium rolfsii; (b) Sclerotium rolfsii only.
Figure 5. Antagonistic activities of Trichoderma viride against Penicillium notatum on PDA at 25˚C. (a) Trichoderma viride + Penicillium notatum; (b) Penicillium notatum only.
Table 2. In vitro antagonistic activities of maize associated fungi on Pythium species at 25˚C on PDA.
inhibition of all the test fungi on malt extract agar except Pythium species with percentage inhibition of 60.74 for both Trichoderma isolates and Aspergillus repens for Trichoderma from maize cob on potato dextrose agar as shown in Table 7.
3.6. Effect of Inoculation Time on Antagonistic Activities of Trichoderma viride
There was increase in the antagonistic property of T. viride when it was inoculated a day and 2 days before S. rolfsii and Pythium sp. (Plates 9 and 10). The antagonistic property of the two isolates of Trichoderma was more
Table 3. In vitro antagonistic activities of maize associated fungi against Sclerotium rolfsii 25˚C on PDA.
Table 4. In vitro antagonistic activities of maize associated fungi against Aspergillus repens on PDA at 25˚C.
Table 5. In vitro antagonistic activities of maize associated fungi against Penicillium notatum on PDA at 25˚C.
pronounced when they were inoculated 2 days before the pathogen The percentage inhibition ranged from 69.26% to 82.22% and 70.69% to 72.41% for Pythium species and Sclerotium rolfsii respectively (Table 8). The results show that was significant differences in inhibitory potentials of the two isolates of Trichoderma viride with increase in inoculation time (Figure 8 and Figure 9).
Values followed by similar alphabet are not significantly different at P ≤ 0.05.
4. Discussion
It is well established that there are large and diverse numbers of bacteria found on plants [5] . However, none of these bacterial isolates was antagonistic against the test pathogens although some of these isolates have been known to show inhibitory effect on some of test pathogens by various researchers [13] [14] . This may be due to strain peculiarity. Foldes et al. [15] showed that out of 25 Bacillus isolates experimented on, only one (4%) exhibited zones of inhibition against phytopathogens and other microorganisms. Todorova and Kozhuharova [16] observed that Bacillus species strain TS 01 did not inhibit the growth of A. niger and Penicillium species.
Figure 6. Effect of mancozeb (1%) on the growth of Aspergillus repens on PDA at 25˚C. (a) Mancozeb + Aspergillus repens; (b) Aspergillus repens only.
Figure 7. Effect of mancozeb (1%) on the growth of Sclerotium rolfsii on PDA at 25˚C. (a) Mancozeb + Sclerotium rolfsii; (b) Sclerotium rolfsii only.
Table 6. Effect of selected fungicides on the test fungal pathogens.
Some of the fungi isolated have been found associated with agricultural systems. Trichoderma viride is associated with rhizosphere although this is the first time to the best of our understanding in which T. viride was isolated from maize cob. Of all test pathogens, S. rolfsii was most susceptible to maize associated fungi followed by Pythium sp. Many groups of fungi are well known as biocontrol agents [17] . Fungi have many mechanisms of action such as growth competition, antibiotic production and mycoparasitism [18] . Although Ghildiyal and Pandey [19] observed that none of the species of Trichoderma showed visible inhibition of pathogenic fungus Pythium afertile, the reverse was the case in this present investigation. The antagonistic ability of Trichoderma spp. may be due to the production of antimicrobial substances, synthesis of hydrolytic enzymes, toxic compounds, or antibiotics and competition for nutrients and ecological niche [20] . Both test pathogens and the antagonistic fungi grew well on both PDA and MEA. However, the growth was best on MEA. Şesan and Oancea
Table 7. Effect of culture media on the % growth inhibition of the test pathogens by selected fungal isolates.
Key: A: Trichoderma viride from rhizosphere soil; B: Trichoderma viride from maize cob; C: Penicillium italicum.

Figure 8. Effect of preinoculation of Trichoderma viride on the growth of Sclerotium rolfsii on PDA at 25˚C. (a) Trichoderma viride was inoculated a day before Sclerotium rolfsii; (b) Trichoderma viride was inoculated 2 days before Sclerotium rolfsii.

Figure 9. Effect of preinoculation of Trichoderma viride on the growth of Pythium spon PDA at 25˚C. (a) Trichoderma viridae was inoculated a day before Pythium sp.; (b) Trichoderma viride was inoculated 2 days before Pythium sp.
Table 8. Effect of inoculation time on the antagonistic activities of Trichoderma species on Sclerotium rolfsii and Pythium sp. at 25˚C.
[21] observed that the most favourable media for growth and sporulation of T. viride, Td50, were Weindling, Warcup, MEA and PDA. There was increase in antagonistic abilities of most of the fungal isolates on MEA. Penicillium notatum was completely inhibited on MEA by T. viride which depicted that might be a factor in the medium that facilitated factors responsible for antagonistic activities of T. viride.
No growth of the test pathogens was observed at 1% (w/v) of mancozeb, camazeb and red force. Sclerotium rolfsii was completely inhibited at 0.05% (w/v) of mancozeb while there was no inhibition when 0.05% of red force was used. Oniango et al. [22] observed that mancozeb was most effective at higher concentrations. Zaker and Mosallenejad [23] also stated that mancozeb completely inhibited the mycelial growth of Altenaria alternata at 0.2%.
There was an increase in antagonistic property of pre-inoculated T. viride against S. rolfsii and Pythium species. Havenga et al. [24] observed that antagonist cells of B. subtilis applied prior to the pathogen, Colletotrichum gloeosporioides resulted in total inhibition of spore germination. Therefore the antagonist's preventative action might be an indication of competitive exclusion or pre-emptive colonization.
5. Conclusion
The present investigation has shown that Trichoderma viride isolated from maize cob was antagonistic to the test fungi. The factors underlying its biocontrol potential and its effect on plant therefore need to be determined.
References
- Vogt, V., Cravero, C., Tonn, C., Sabini, L. and Rosas, S. (2010) Verbascum Thapsus: Antifungal and Phytotoxic Properties. IDECEFYN, 20, 105-108.
- Nguyen, V.N., Nguyen, D.M.C., Seo, D.J., Park, R.D. and Jung, W.J. (2009) Antimycotic Activities of Cinnamon-De- rived Compounds against Rhizoctonia solani in Vitro. BioControl, 54, 697-707. http://dx.doi.org/10.1007/s10526-009-9220-2
- Gerhardson, B. (2002) Biological Substitutes for Pesticides. Trends in Biotechnology, 20, 338-343. http://dx.doi.org/10.1016/S0167-7799(02)02021-8
- Daayf, F., Adam, L. and Fernando, W.G.D. (2003) Comparative Screening of Bacteria for Biological Control of Potato Late Blight (Strain US-8) Using in Vitro, Detached Leaves and Whole Plant Systems. Canadian Journal of Plant Pathology, 25, 276-284. http://dx.doi.org/10.1080/07060660309507080
- Gnanimanicakam, S., Ed. (2007) Plant-Associated Bacteria. Springer, New York.
- Li, B.C. and Sutton, J.C. (1995) Evaluation of Leaf-Associated Microorganisms for Biocontrol of Tan Spot in Wheat Foliage. Fitopatologia Brasileira, 20, 545-552.
- Manjula, K., Mwangi, M. and Bandyopadhyay, R. (2005) Potential of Some Bacteria and Fungi as Biocontrol Agents of Cassava and Yam Tuber Rot Pathogens under Laboratory and Green House Conditions. African Crop Science Conference Proceedings, 7, 1395-1400.
- Adetuyi, F.C. (1985) Studies on Microorganisms Endemic to Cereal Seeds. Ph.D. Thesis, University of London, London, 143-183.
- Bhaskar, C., Pandey, A., Palni, L.M.S., Trivedi, P., Kumar, B. and Colvin, N. (2005) Diffusible and Volatile Compounds Produced by an Antagonistic Bacillus subtilis Strain Cause Structural Deformations in Pathogenic Fungi in Vitro. Microbiological Research, 160, 75-81. http://dx.doi.org/10.1016/j.micres.2004.09.013
- Caldari Jr., P. (1998) Morphological Characterization, Sensitivity to Fungicides and Sporulation of Botrytis cinerea Isolates of Flowers and Ornamental Plants. Dissertation (Master in Plant Pathology), School of Agriculture Luiz de Queiroz, Universidade de Sao Paulo, Piracicaba. In: De Figueirêdo, G.S., De Figueirêdo, L.C., Cavalcanti, F.C.N., Dos Santos, A.C., Da Costaand, A.F. and De Oliveira, N.T., Eds., Biological and Chemical Control of Sclerotinia sclerotiorum Using Trichoderma spp. and Ulocladium atrum and Pathogenicity to Bean Plants, Brazilian Archives of Biology and Technology, 53, 1-9.
- Gomathi, S. and Ambikapathy, V. (2011) Antagonistic Activity of Fungi against Pythium debaryanum Hesse) Isolated from Chilli Field Soil. Advances in Applied Science Research, 2, 291-297.
- Spotts, R.A. and Chand-Goyal, T. (1997) Combinations of Biocontrol Yeasts and Eradicant Activity of Yeasts for Postharvest Pear Diseases (Abstract). Phytopathology, 87, 593.
- Nalisha, I., Muskhazli, M. and Nor Farizan, T. (2006) Production of Bioactive Compounds by Bacillus subtilis against Sclerotium rolfsii. Malaysian Journal of Microbiology, 2, 19-23.
- Rakh, R.R., Raut, L.S., Dalvi1, S.M. and Manwar, A.V. (2011) Biological Control of Sclerotium rolfsii, Causing Stem Rot of Groundnut by Pseudomonas cf. Monteilii 9. Recent Research in Science and Technology, 3, 26-34.
- Foldes, T., Banhegye, I., Herpai, Z., Varga, L. and Szigeti, J. (2000) Isolation of Bacillus Strain from the Rhizosphere of Cereals and in Vitro Screening for Antagonism against Phytopathogenic Food Borne and Spoilage Microorganisms. Journal of Applied Microbiology, 89, 840-846.
- Todorova, S. and Kozhuharova, L. (2010) Characteristics and Antimicrobial Activity of Bacillus subtilis Strains Isolated from Soil. World Journal of Microbiology and Biotechnology, 26, 1207-1216. http://dx.doi.org/10.1007/s11274-009-0290-1
- Thanaboripa, D., Sappakitjanon, N., Prommi, L. and Chareonsettasilp, S. (2009) Screening of Fungi for the Control of Aspergillus parasiticus. KMITL Science and Technology Journal, 9, 95-102.
- Thanaboripat, D. (2002) Importance of Aflatoxins. KMITL Science Journal, 2, 38-45.
- Ghildiyal, A. and Pandey, A. (2008) Isolation of Cold Tolerant Antifungal Strains of Trichoderma sp. from Glacial Sites of Indian Himalayan Region. Research Journal of Microbiology, 3, 559-564. http://dx.doi.org/10.3923/jm.2008.559.564
- Benítez, T., Rincón, A.M., Limón, M.C. and Codón, A.C. (2004) Biocontrol Mechanisms of Trichoderma Strains. International Microbiology, 7, 249-260.
- Şesan, T.E. and Oancea, F. (2010) Trichoderma viride Pers.―Experimental Model for Biological and Biotechnological Investigations of Mycromyceta with Importance in Obtaining Plant Protection Bioproducts. Journal of Plant Development, 17, 49-62.
- Oniang’o, M.O., Khare, K.B., Achwanya, O.S. and Otieno, W. (2005) Efficacy of Synthetic and Non-Synthetic Fungicides against Stem Canker Disease of Tea. African Crop Science Journal, 13, 209-214. (Short Communication)
- Zaker, M. and Mosallanejad, H. (2010) Antifungal Activity of Some Plant Extracts on Alternaria alternata, the Causal Agent of Alternaria Leaf Spot of Potato. Pakistan Journal of Biological Sciences, 13, 1023-1029. http://dx.doi.org/10.3923/pjbs.2010.1023.1029
- Havenga, W., De Jager, E.S. and Korsten, L. (1999) Factors Affecting Biocontrol Efficacy of Bacillus subtilis against Colletotrichum gloeosporioides. South African Avocado Growers’ Association Yearbook, 22, 12-20.
NOTES
*Corresponding author.






